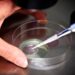
IVF clinic admits embryo mix-up as mother gives birth to another patient’s baby

An Abuja High Court on Tuesday awarded N100 million in general damages against Louisville Girls Secondary School, Gwagwalada, for negligence of duty of care which led to the death of a student.
Justice Sylvanus Oriji delivered the judgment in a suit filed by Ifeanyi Ikpeatusim, who accused the school of negligence that resulted in the death of his nine-year-old daughter, Kamzie.
In the suit marked CV/1738/18, Mr Ikpeatusim alleged that the school’s failure to provide adequate medical attention after Kamzie fell ill shortly after her admission led to her untimely death.
Kamzie was admitted as a boarding student in September 2017 and became severely ill by October 2. She died a few days later.
Justice Oriji held that the evidence presented clearly showed the school and its agents acted negligently by failing to attend promptly and adequately to Kamzie’s medical needs.
“The claimant established his allegations of negligence against the school. There is no amount of money that can bring back the child to life,” the judge ruled.
The court awarded N100 million as general damages and ordered a 10 per cent interest on the judgment sum from April 8 until full payment.
An additional N300,000 was awarded as the cost of the suit.
Justice Oriji noted that one significant outcome of the case was the improvement of the school’s sickbay following the incident.
He remarked that the presence of doctors attending to students twice daily was a commendable development.
The claimant requested that a school structure be named in honour of Kamzie.
Mr Oriji said: “The court is of the opinion that the improvement in the sickbay, ensuring doctors are available twice daily, is in honour of Kamzie, as part of reforms recommended by her family. The claimant should take solace in the fact that Kamzie has been honoured by the school through these improvements.”
(NAN)